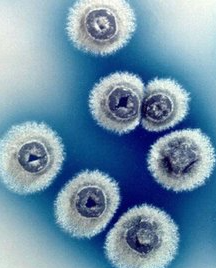
次氯酸水可有效去除霉菌 次氯酸水可有效去除霉菌

酸性電解水能有效去除霉菌
霉菌作為生活中常見的一類微生物,是形成分枝菌絲類真菌的統稱,它們往往能形成分枝繁茂的菌絲體,但又不象蘑菇那樣產生大型的子實體。霉菌喜溫喜濕,在溫暖和潮濕環境下都能夠生長和繁殖,因此食物、飼料、家具、衣物,甚至墻面、地板在潮濕的季節都極容易發生霉變。
其中,部分霉菌在生長繁殖過程中會產生一類有毒性的次級代謝產物,稱之為霉菌毒素。這些霉菌毒素通過食品、飼料等進入人和動物體內,引起人和動物的急性或慢性毒性,損害機體的肝臟、腎臟、神經組織、造血組織及皮膚組織等,從而威脅生物體生命。目前發現約有150余種可以產生毒素的霉菌,所產生的霉菌毒素種類超過300種,其中就最著名的就是“頭號殺手“黃曲霉毒素。
微酸性電解水對黑霉的防治效果
日本東京大學Angelica Naka研究小組評估了微酸性電解水對于家庭環境中所形成霉菌的去除效果,研究采用了40mg/L的微酸性電解水進行清洗,發現清洗后能夠有效降低芽枝狀枝孢菌、膠紅酵母等真菌,存活量降低超多2個數量級;其中,芽枝狀枝孢菌呈明顯的黑色,也常被稱之為黑霉,多產生于墻面或風口處,因此該研究中以家用網格板中已產生的黑霉作為實驗對象,利用40mg/L微酸性電解水進行清洗,連續清洗5次后可將黑霉徹底清除,效果顯著優于普通自來水。該研究表明,微酸性電解水非常適合用于家庭中的物表消毒。

微酸性電解水對灰葡萄孢菌的防治效果
浙江大學朱松明教授團隊曾對灰葡萄孢菌(常見的植物霉菌之一)進行研究,發現利用30mg/L的微酸性電解水處理10min后,即可使灰葡萄孢菌的滅活率達到99.99%;連續對形成的灰葡萄孢菌落進行處理3天后,能殺滅灰葡萄孢的新生孢子并抑制其菌絲生長,在此過程中,菌絲逐漸變暗黃、枯萎,直至死亡,菌落停止生長。
利用掃描透射電鏡對其殺滅機理進行研究,發現微酸性電解水處理會導致灰葡萄孢菌的孢子細胞發生質壁分離,細胞質溢出,細胞器溶解,細胞皺縮,從而使其失活而被徹底殺滅。
微酸性電解水對灰黃曲霉的防治效果
中國農業大學李里特教授團隊曾針對黃曲霉進行了一系列研究,發現微酸性電解水能破壞黃曲霉分生孢子和菌絲的細胞結構,導致細胞內K+和Mg2+泄漏,進而對黃曲霉分生孢子和菌絲有較強殺滅和抑制作用;除此以外,采用微酸性電解水浸泡,還可有效降解天然污染花生中黃曲霉毒素B(AFB1),降解率達到85%。

綜合來看,微酸性電解水在霉菌防治方面具有良好的應用效果和潛力,不僅對多數霉菌具有顯著的殺滅和抑制效果,還能降低霉菌毒素含量,有效控制霉菌毒素對人體的威脅風險,從而提升人們的生活安全品質。
盛懷電解水設備已經遠銷國內外、歐美、東南亞、中東等國家,憑借精湛的工藝、研發投入和完善的售后,陸續推向市場稀鹽酸款次氯酸發生器、氯化鈉款次氯酸發生器、氯化鉀款次氯酸發生器、碳酸鉀款次氯酸發生器,已在醫療、教育、畜牧養殖、農業種植、工業清洗等領域案例眾多。
了解更多,可以留下您的聯系方式或聯系我們:19953182842,將竭誠為您服務!





